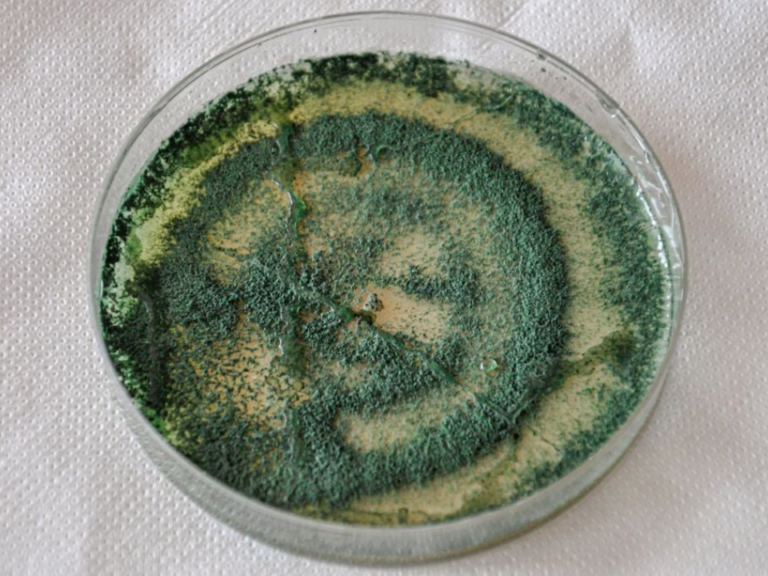

Pesquisadores brasileiros desenvolveram uma solução inovadora e sustentável usando farinha de arroz quebrado para produzir grânulos com Trichoderma asperelloides, capazes de controlar fungos nocivos em plantações e aumentar a durabilidade dos bioinsumos no solo.
No campo da agricultura moderna, a busca por soluções sustentáveis não é mais apenas uma tendência, é uma necessidade urgente. Em meio a esse desafio, um grupo de pesquisadores brasileiros desenvolveu uma tecnologia inovadora que promete revolucionar o controle de pragas fúngicas nas plantações, o chamado “biorreator em um grânulo”.
Essa nova técnica, liderada por cientistas da Embrapa, da Universidade Estadual Paulista (UNESP), da Universidade Federal de São Carlos (UFSCar) e da USP, utiliza o fungo Trichoderma asperelloides, um microrganismo já conhecido por suas propriedades benéficas à agricultura, mas agora apresentado em uma formulação inédita e sustentável.
O estudo foi publicado recentemente na revista Applied Microbiology and Biotechnology e apresenta uma proposta ambiciosa, substituir métodos convencionais de produção do Trichoderma por um sistema mais barato, eficiente e ecologicamente correto. Em vez de utilizar grãos integrais de arroz ou outros cereais, que são insumos caros e de importância alimentar, os pesquisadores recorreram à farinha de arroz obtida a partir do arroz quebrado, um subproduto muitas vezes desperdiçado na indústria.
Como funciona o “biorreator em um grânulo”?
A ideia central da pesquisa foi criar pequenas cápsulas secas, parecidas com grânulos, que funcionam como minifábricas naturais. Cada grânulo contém tudo o que o fungo Trichoderma precisa para crescer e se multiplicar quando reidratado no solo. Isso permite que ele atue diretamente no ambiente agrícola, combatendo fungos patógenos como o Sclerotinia sclerotiorum, que causa o mofo branco em diversas culturas.
Essa inovação traz uma vantagem dupla, além de eliminar a necessidade de extrair os esporos do fungo, o que é um processo caro e que gera resíduos, o grânulo mantém os compostos bioativos produzidos durante a fermentação, potencializando a ação do Trichoderma. O resultado é um produto que age de forma eficaz, com alta durabilidade e pronto para aplicação direta no solo.
Um produto sustentável, com longa duração e fácil aplicação
A estabilidade do produto foi um dos pontos mais impressionantes do estudo. Algumas formulações mantiveram sua viabilidade por até 24 meses quando armazenadas em temperaturas refrigeradas, sem perda significativa da capacidade de controlar o fungo alvo. Entre os ingredientes testados para compor os grânulos, destacaram-se a bentonita, um tipo de argila, e compostos orgânicos ricos em nutrientes naturais.
As vantagens dessa formulação incluem:
- Uso de resíduos agroindustriais como matéria-prima, como a farinha de arroz quebrado
- Alta durabilidade dos grânulos, com eficácia mesmo após dois anos de armazenamento
- Redução no uso de fungicidas químicos, contribuindo para uma agricultura mais limpa
- Fácil manuseio e aplicação no solo, sem necessidade de equipamentos complexos
- Potencial de liberação lenta do microrganismo, o que garante ação prolongada
Essa combinação de sustentabilidade, eficácia e praticidade é um passo importante rumo a uma agricultura regenerativa e menos dependente de insumos químicos.
Impacto para o Brasil, agricultura mais verde e acessível
Para um país como o Brasil, onde o agronegócio representa uma parte significativa da economia e da exportação, essa tecnologia tem um potencial transformador. O uso de microrganismos como o Trichoderma já é comum em práticas agroecológicas e produção orgânica, mas sua adoção ainda esbarra em custos e limitações logísticas. Com essa nova forma de produção e formulação, esses obstáculos podem ser superados.
Além disso, aproveitar subprodutos como o arroz quebrado, que representa até 15 por cento do total processado, traz uma solução inteligente para o reaproveitamento de resíduos da cadeia produtiva.
Essa pesquisa mostra como ciência, criatividade e compromisso ambiental podem se unir para criar soluções reais para os desafios do campo. O “biorreator em um grânulo” é mais do que uma inovação científica, é uma promessa de futuro mais sustentável para a agricultura brasileira.
Referência da notícia
Innovative sustainable bioreactor-in-a-granule formulation of Trichoderma asperelloides. 4 de setembro, 2024. Silva, L.G., Camargo, R.C., Mascarin, G.M. et al.
Matéria – Diego Portalanza
Imagem – Cultura de Trichoderma em placa de Petri, fungo amplamente usado no controle biológico de pragas agrícolas.